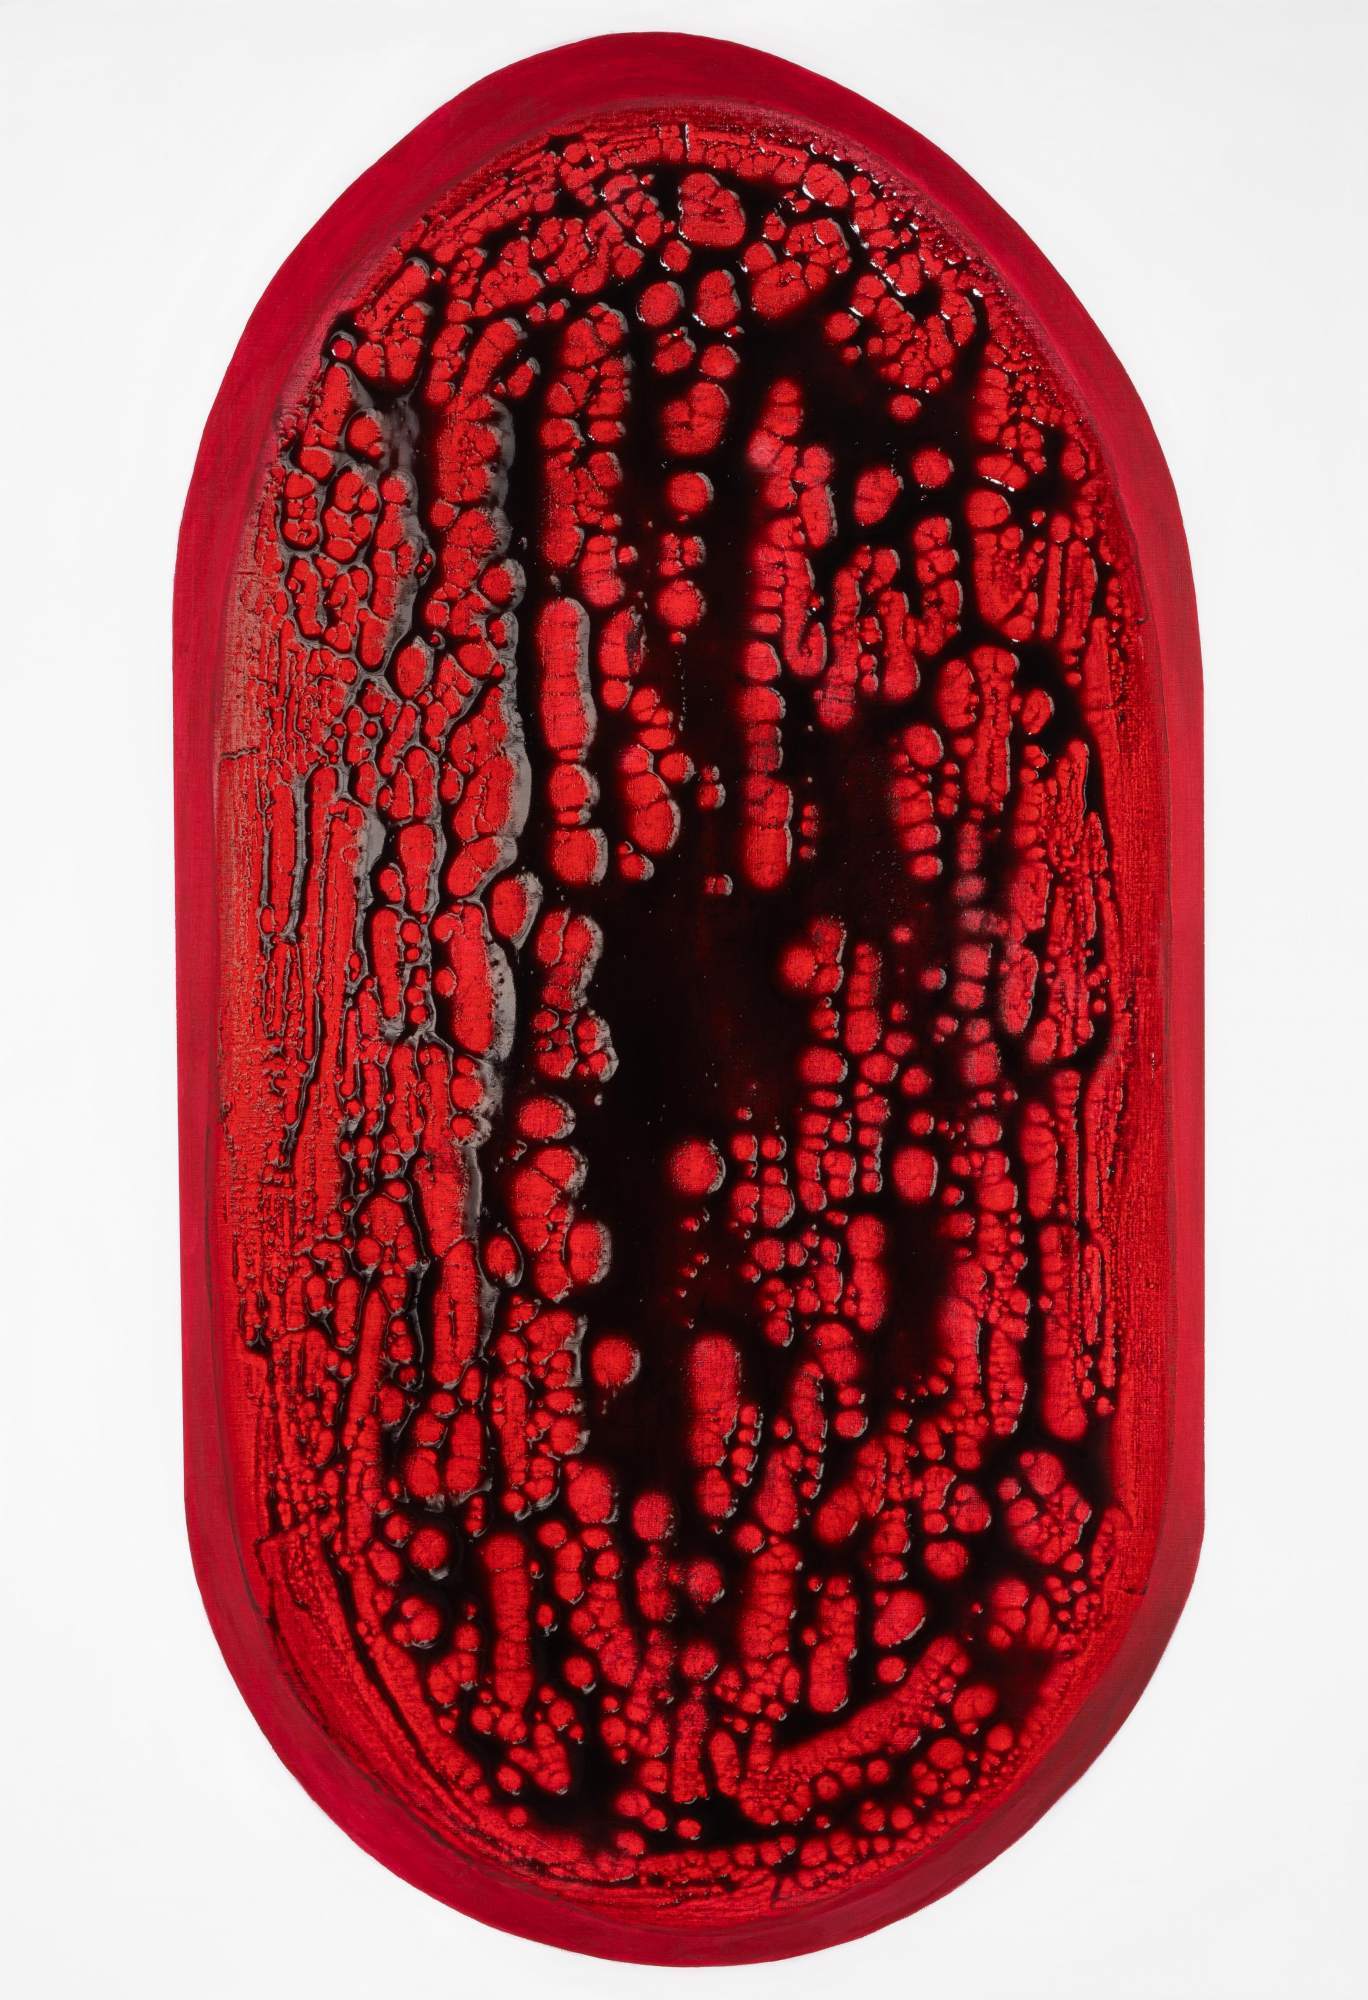

Bio
Kami Mierzvvinsk’s work explores themes of minorities and social exclusion through a performative painting practice deeply rooted in East Asian transcendental traditions. Their subjects arise from trance-like states of deep concentration. Drawing on the concept of anamnesis—the act of recalling innate knowledge from before the soul joined the body—Mierzvvink's art emphasizes the spirit and its fluid, genderless nature. Their technique creates a dynamic shift in scale on the surface as the viewers are constantly confronted with new depths beneath the gestural strokes.
Exhibitions
2025
From Blood (solo) ZOYA Museum Modra, SK
Where the Night Softens (solo)Galerie Noah Klink Berlin DE
2023
Edges of the Worlds (solo) B93 Enschede, NL
My Body Is Your Body Braunsfelder Cologne, DE
2022
Listasyning Skrufan Eyrarbakki, IL
My problem is a woman’s problem: voices of the younger generation Centrala Spaces Birmingham, UK
2021
Milky Way MIA Gallery Wroclaw, PL
Ewa Partum. My problem is a woman’s problem Fabryka Sztuki Łódź, PL
Tolerance(s), ArtiFactory Eos Gallery Athens, GR
National Best Diplomas of the Academy of Fine Arts 2020 Zbrojownia Sztuki Gdansk, PL
2020
Life isn’t everything (solo) Contemporary Art Gallery MD_S Wroclaw, PL
International Student’s Drawing Triennial Rondo Sztuki Gallery Katowice, PL
Drawing Connection Lower Rowe Gallery Department of Art & Art History Charlotte, US
2019
Third International Student Biennale Lauba Zagreb, HR
XI Small Painting Forms Triennial Gallery Wozownia Torun, PL
7th International Pastel Biennale BWA Sokół Contemporary Art Gallery Nowy Sącz, PL
Homography / Homography Festival ArtSpace México Mexico City, MX
Extending Reality Amart Gallery Vienna, AT
2018
Auditorium Comicum Museum of the University of Wroclaw Wroclaw, PL
Night on Earth Contemporary Art Gallery MD_S Wroclaw, PL
2017
How is it? Gallery Labyrinth Lublin, PL
2016
NOTO Gallery of the New Art Foundation Krakow, PL
2013
Commencement (solo) industrial storage space Wroclaw, PL
CV
Download CVPress
Works
-

Kami Mierzvvinsk ITTOD 2025 Mixed media on linen canvas 40 × 30 cm 15 3/4 × 11 3/4 inches
-

Kami Mierzvvinsk OPBW 2025 Mixed media on linen canvas 40 × 30 cm 15 3/4 × 11 3/4 inches
-

Kami Mierzvvinsk NE.ADBU 2025 Mixed media on linen canvas 40 × 30 cm 15 3/4 × 11 3/4 inches
-

Kami Mierzvvinsk MP(AW) 2025 Mixed media on linen canvas 40 × 30 cm 15 3/4 × 11 3/4 inches
-

Kami Mierzvvinsk K 2024 Mixed techniques on canvas 180 × 300 cm 70 7/8 × 118 1/8 inches
-

Kami Mierzvvinsk TMON 2024 Mixed media on canvas 13 × 13 cm 5 1/8 × 5 1/8 inches
-

Kami Mierzvvinsk wtnwkwms 2024 Mixed media on canvas 160 × 110 cm 63 × 43 1/4 inches
-

Kami Mierzvvinsk P(SMN) 2024 Mixed media on canvas 150 × 150 cm 59 × 59 inches
-

Kami Mierzvvinsk ooo ooo 2024 Mixed media on canvas 160 × 110 cm 63 × 43 1/4 inches
-

Kami Mierzvvinsk pdknbzsd 2024 Mixed media on canvas 160 × 110 cm 63 × 43 1/4 inches
-

Kami Mierzvvinsk owb 2024 Mixed media on canvas 160 × 110 cm 63 × 43 1/4 inches
-
Kami Mierzvvinsk WMW 2024 Mixed media on canvas 160 × 110 cm 63 × 43 1/4 inches
-

Kami Mierzvvinsk YY 2024 Mixed media on canvas 59 × 59 cm 23 1/4 × 23 1/4 inches
-

Kami Mierzvvinsk QK KPWP 2024 Mixed media on canvas 200 × 150 cm 78 3/4 × 59 inches
-

Kami Mierzvvinsk B(lslf) 2023 Mixed media on canvas 180 × 180 cm 70 7/8 × 70 7/8 inches